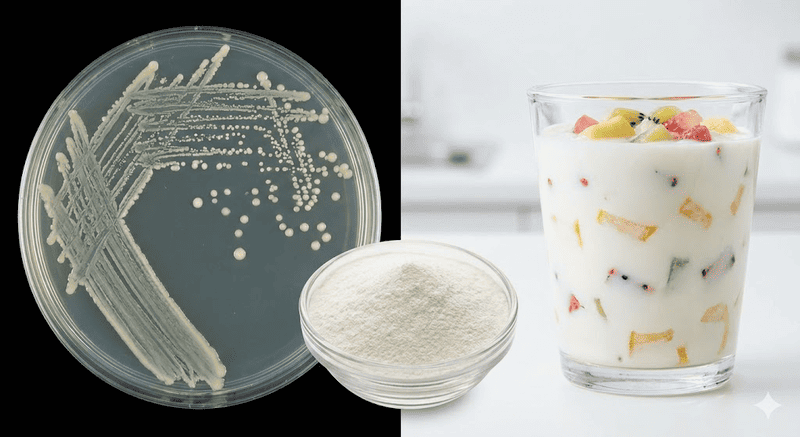
chất ổn định trong sữa chua

Chất ổn định trong sữa chua – Bí quyết giữ kết cấu sánh mịn
Độ sánh mịn, kết cấu ổn định là yếu tố then chốt quyết định chất lượng sữa chua. Việc sử dụng chất ổn định trong sữa chua giúp duy trì cấu trúc gel, hạn chế tách nước và đảm bảo đồng nhất trong quá trình sản xuất và bảo quản. Cùng Hùng Duy Starch khám phá các phụ gia thực phẩm giúp sữa chua giữ được kết cấu đặc – mịn – ổn định trong mọi điều kiện sản xuất.
1. Đặc tính căn bản về kết cấu của sữa chua
Sữa chua có màu trắng sữa hoặc màu đặc trưng của phụ liệu, có thể kèm hương trái cây hoặc hương liệu thực phẩm. Khi ăn mang lại cảm giác mát, sánh đặc, đồng nhất, không tách nước, không vón cục, độ chua hài hòa và dễ chịu.
Đặc tính này được hình thành nhờ quá trình lên men lactic bởi Lactobacillus bulgaricus và Streptococcus thermophilus, trong đó vi khuẩn chuyển đường lactose thành axit lactic làm giảm pH và khiến casein trong sữa đông tụ lại thành mạng lưới gel ba chiều.

2. Các loại chất ổn định trong sữa chua thường gặp
2.1. Pectin (E440)
Pectin là một polymer carbohydrate có nguồn gốc tự nhiên, chủ yếu từ vỏ cam quýt, thường được dùng trong sản xuất sữa chua trái cây hoặc sữa chua uống. Vai trò của chất ổn định trong sữa chua pectin:
- Giảm tách nước, tách whey trong quá trình lên men và bảo quản.
- Ổn định protein, tăng độ nhớt và tạo cấu trúc gel nhẹ.
- Cải thiện cấu trúc cảm quan: mịn, sệt, đồng nhất.

2.2. Carrageenan
Carrageenan là polysaccharide được chiết xuất từ tảo đỏ, được dùng rất phổ biến trong sản xuất sữa chua có hương vị, sữa chua uống hoặc sữa chua ít béo với tên gọi chất ổn định E407. Lợi ích khi ứng dụng Carrageenan trong sữa chua:
- Tăng độ mịn, sánh, dẻo mà không phải tăng chất béo/
- Hỗ trợ tạo kết cấu đồng nhất, mềm mượt, giúp sản phẩm hấp dẫn hơn.
- Ổn định protein, giữ nước, hạn chế tách lớp và giảm thất thoát whey trên bề mặt sữa chua, đặc biệt trong vận chuyển/bảo quản lạnh.

2.3. Gelatin
Gelatin là protein thu được từ da và xương động vật, có khả năng tạo gel nhẹ, độ đàn hồi tốt. Đây là chất ổn định truyền thống, được sử dụng nhiều trong các sản phẩm sữa chua để:
- Tạo độ đặc, dẻo và mượt mà cho sản phẩm.
- Hạn chế tách nước trong quá trình bảo quản.
- Ổn định cấu trúc gel tự nhiên của sữa chua ăn.
- Tăng cảm giác ngon miệng nhờ độ đàn hồi nhẹ.

2.4. CMC (Carboxymethyl cellulose)
CMC là polymer cellulose được biến tính, mang điện tích âm, trơ về mặt sinh lý, bền trong môi trường acid. Đây là một trong những chất ổn định linh hoạt nhất cho sữa chua uống vì có khả năng:
- Tăng độ nhớt mạnh, giữ nước tốt, giảm tách whey, hạn chế kết tụ, giúp sản phẩm duy trì độ sánh và kết cấu đồng nhất trong suốt thời gian bảo quản.
- Không làm thay đổi pH và không ảnh hưởng đến vi khuẩn lên men.

2.5. Gellan gum
Gellan gum là polysaccharide do vi khuẩn Sphingomonas elodea tạo ra. Chất này dễ phân tán, hydrat hóa khi gia nhiệt và tạo độ nhớt cao.
Lợi ích khi sử dụng Gellan gum là chất ổn định trong sữa chua uống, đồ uống sữa acid hóa, hoặc sữa chua hương trái cây có thịt quả:
- Tạo gel mạnh ở nồng độ thấp, ổn định cấu trúc.
- Tăng khả năng giữ nước, giảm tách whey.
- Tăng độ nhớt và giúp treo hạt trái cây trong sữa chua.
- Giúp sản phẩm đồng nhất và bền trong suốt quá trình bảo quản.
2.6 Tinh bột biến tính
Tinh bột biến tính (Modified Starch) là tinh bột đã được xử lý bằng phương pháp vật lý, hóa học hoặc enzyme nhằm cải thiện đặc tính mà tinh bột nguyên bản không có, như:
- Khả năng kháng axit
- Khả năng chịu lực cắt và khuấy trộn
- Độ bền nhiệt
- Khả năng giữ nước và ổn định gel
Lợi ích của việc sử dụng tinh bột biến tính như là chất ổn định trong sữa chua:
- Cải thiện cảm giác miệng, giúp sữa chua ít béo hoặc tách béo có cấu trúc mượt – dày – béo hơn.
- Chịu axit, chịu được lực cắt mạnh, duy trì kết cấu đặc – sánh – mịn – dẻo cho sữa chua khuấy vốn rất dễ bị tách whey
- Giữ cấu trúc ổn định, giúp sữa chua trái cây, sữa chua uống sau làm lạnh vẫn dẻo – mịn – không tách nước, tách lớp, tách topping.
- Giảm chi phí công thức nhờ khả năng tạo đặc mạnh ở liều thấp, cho phép giảm bớt lượng chất ổn định khác hoặc hạn chế tăng chất khô từ sữa.
- Tối ưu hiệu suất sản xuất nhờ hoạt động ổn định trong nhiều điều kiện, giảm lỗi mẻ so với sử dụng gelatin hoặc tinh bột tự nhiên.
- Hỗ trợ kiểm soát hệ vi sinh nhờ tạo nền gel ổn định, hạn chế hao hụt ẩm và pH.

Theo Thông tư 24/2019/TT-BYT của Bộ Y tế, tinh bột biến tính được phép sử dụng trong sữa chua với chức năng chất làm đặc, chất làm dày, chất ổn định. Việc sử dụng phải bảo đảm hiệu quả kỹ thuật (như tạo độ đặc, ổn định gel, cải thiện cấu trúc), không dùng để che giấu chất lượng sản phẩm, không gây ảnh hưởng sức khỏe, ghi nhãn đầy đủ và tuân thủ mức dùng tối đa (ML) hoặc theo GMP tùy nhóm phụ gia.
Các loại tinh bột biến tính thường được dùng trong sản xuất sữa chua:
- E1422 – Acetylated Distarch Adipate: Ổn định tốt trong môi trường axit; giảm tách nước; tăng độ đặc, sánh, mịn, cải thiện cảm giác miệng và mô phỏng độ béo cho sữa chua ít béo hoặc non-fat.
- E1442 – Hydroxypropyl Distarch Phosphate: Ổn định trong điều kiện pH thấp, giữ cấu trúc dẻo, không bị vón hoặc tách lớp, giúp sữa chua trái cây, sữa chua Hy Lạp duy trì kết cấu đồng nhất trong suốt vòng đời sản phẩm.

3. Đơn vị cung cấp giải pháp tinh bột biến tính ổn định cho ngành thực phẩm
Hùng Duy Starch là đơn vị tiên phong trong sản xuất tinh bột mì và tinh bột mì biến tính tại Việt Nam, với hơn 55 năm kinh nghiệm, hệ thống nhà máy hiện đại tại Tây Ninh và liên kết vùng nguyên liệu Campuchia. Công ty cung cấp giải pháp tinh bột biến tính chất lượng cao, giúp duy trì kết cấu đồng nhất, sánh mịn và ổn định cho các sản phẩm sữa chua, đặc biệt trong điều kiện bảo quản lạnh hay sản phẩm ít béo.
Thế mạnh nổi bật của Hùng Duy Starch:
- Năng lực thương mại & xuất khẩu quốc tế: Hùng Duy sở hữu kinh nghiệm xuất khẩu lâu năm sang nhiều thị trường khó tính như Mỹ, Châu Âu, Nhật Bản, Hàn Quốc… Dịch vụ logistics linh hoạt (FOB/ CFR/ CIF/ Door-to-door) kết hợp quản lý chứng từ chuyên nghiệp giúp giao hàng đúng tiến độ, giảm rủi ro cho đối tác.
- Chuỗi cung ứng nguyên liệu ổn định & chất lượng cao: Nguồn củ mì tươi từ Tây Ninh kết hợp liên kết bền vững với Campuchia giúp đảm bảo nguyên liệu đồng nhất, chất lượng vượt trội. Kinh nghiệm nhập khẩu, kiểm dịch và vận hành xuyên biên giới giúp duy trì chuỗi cung ứng ổn định quanh năm.
- Sản xuất tinh bột biến tính hiện đại, đa dạng sản phẩm: Hùng Duy làm chủ công nghệ và sản xuất hơn 20 loại tinh bột biến tính (E1422, E1442…), đáp ứng yêu cầu giữ cấu trúc gel, tăng độ sánh – mịn – ổn định cho sữa chua, đặc biệt các sản phẩm trái cây, Hy Lạp hay sữa chua ít béo.
- Hệ thống kho vận 50.000 tấn & logistics toàn diện: Hệ thống kho lớn và dịch vụ logistics tích hợp tối ưu giúp cung ứng liên tục, chủ động, đáp ứng nhu cầu sản xuất và xuất khẩu, đồng thời giảm thiểu rủi ro trong quá trình lưu thông hàng hóa.

Hãy kết nối với Hùng Duy Starch để nhận hỗ trợ kỹ thuật và giải pháp cung ứng tinh bột biến tính cho sản phẩm của bạn.
- Ms. Uyên: (+84) 919 998 997
- Mr. Michael: (+84) 916 611 369










Bạn vui lòng đăng nhập để được bình luận.